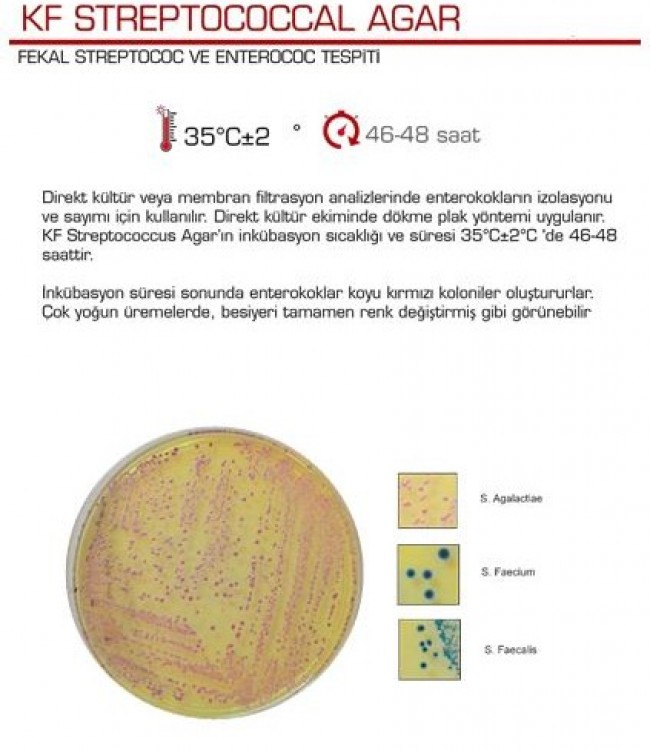
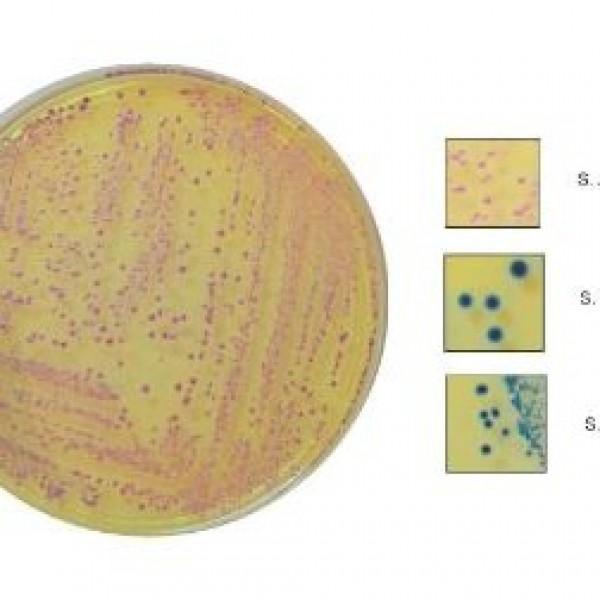

KF Streptococcal Agar
KF STREPTOCOCCAL AGAR
FEKAL STREPTOCOC VE ENTEROCOC TESPİTİ
Direkt kültür veya membran filtrasyon analizlerinde enterokokların izolasyonu
ve sayımı için kullanılır. Direkt kültür ekiminde dökme plak yöntemi uygulanır.
KF Streptococcus Agar’ın inkübasyon sıcaklığı ve süresi 35C +-2C'de 46-48
saattir.
İnkübasyon süresi sonunda enterokoklar koyu kırmızı koloniler oluştururlar.
Çok yoğun üremelerde, besiyeri tamamen renk değiştirmiş gibi görünebilir